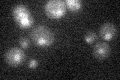

View description
Subunit of RNase MRP, which cleaves pre-rRNA and has a role in cell cycle-regulated degradation of daughter cell-specific mRNAs; binds to the NME1 RNA subunit of RNase MRP
Localization:
Intensity:
Fold change:
Significance:
-
C’ GFP library in SD

nucleus25.93 -
N' NOP1pr-GFP in SD

nucleus20.5628 -
N' TEF2pr-mCherry in SD

nucleus7.98557 -
N' NATIVEpr-GFP in SD

nucleus19.7864 -
N' TEF2pr-VC and Cyto-VN in SD

below threshold23.5861 -
C’ GFP library in SD+DTT

nucleus21.880.84No -
C’ GFP library in SD+H2O2

nucleus22.370.86No -
C’ GFP library in Starvation Media
nucleus19.320.74Yes -
C’ GFP library on the background of Pup2-DaMP

nucleus -
C’ GFP library on the background of CCT mutant

nucleus23.15510.89258No
